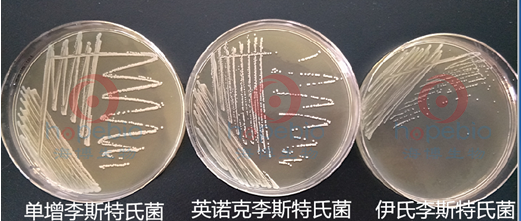

海博微信公众号
海博微信公众号
 海博天猫旗舰店
海博天猫旗舰店


 海博微信公众号
海博微信公众号
 海博天猫旗舰店
海博天猫旗舰店




该培养基用于单增李斯特氏菌的分纯培养,也可用于做7%羊血琼脂。
二、培养基成分(g/L)
|
胰蛋白胨 |
17.0 |
|
多价胨 |
3.0 |
|
酵母浸粉 |
6.0 |
|
氯化钠 |
5.0 |
|
磷酸氢二钾 |
2.5 |
|
葡萄糖 |
2.5 |
|
琼脂 |
15.0 |
|
pH值 7.3 ± 0.1 |
|
三、使用方法
1.称取本品51.0g,加热溶解于1000ml蒸馏水,121℃高压灭菌15分钟备用。
2.取质控菌的新鲜培养物划线接种于平板,于30±1℃培养48h,观察结果。
四、质量控制及结果判定
1.外观方面
干粉培养基:淡黄色粉末。
2.生物学方面
接种以下质控菌株,放置30±1℃需氧培养48小时。结果如下(表格和图片):

五、注意事项
检测之后的培养物必须严格控制,及时置于121℃下高压灭菌1小时后丢弃。
相关产品:
含0.6%酵母膏的胰酪胨大豆琼脂(TSA-YE)-点击查看产品详情
注:本文属海博生物原创,未经允许不得转载。
上一篇:玫瑰红钠琼脂培养基原理和使用方法
| 相关文章: | |
| 含0.6%酵母膏的胰酪胨大豆肉汤的使用介绍 | |



